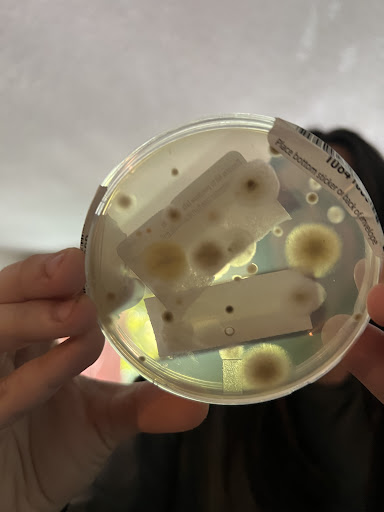

Beach City things to do, attractions, restaurants, events info and trip planning

Basic Info
Beach City
831 Cliff Dr #100, Santa Barbara, CA 93109
3.6(116)
Open until 4:00 PM
Save
spot
spot
Ratings & Description
Info
Outdoor
Relaxation
Scenic
Family friendly
Pet friendly
attractions: Leadbetter Beach, Santa Barbara Carriage and Western Art Museum, La Playa Stadium, Pershing Park, Leadbetter Beach, Ledbetter Beach, Santa Barbara Harbor, Santa Barbara Maritime Museum, Outdoors Santa Barbara Visitor Center, Harbor Patrol, restaurants: Shoreline Cafe, Pressed Juicery, Brophy Bros., On The Alley, Toma Restaurant & Bar, Rudy's Mexican Restaurant, The Anchor Rose, Sushi Go Go, Gracie, The Brewhouse, local businesses: Hope Santa Barbara, Santa Barbara City College, El Rey Santa Barbara Carniceria, J J's Liquor & Wine, Santa Barbara Computer Repair, Santa Barbara Sailing Center, Santa Barbara Channel Charters, Saturday Fishermen's Market of Santa Barbara, Santa Barbara Harbor, Boat Launch Mini Mart
 Learn more insights from Wanderboat AI.
Learn more insights from Wanderboat AI.Phone
(805) 705-7924
Website
stgeorgeassociates.com
Open hoursSee all hours
Fri10 AM - 4 PMOpen
Plan your stay

Pet-friendly Hotels in Santa Barbara
Find a cozy hotel nearby and make it a full experience.

Affordable Hotels in Santa Barbara
Find a cozy hotel nearby and make it a full experience.

The Coolest Hotels You Haven't Heard Of (Yet)
Find a cozy hotel nearby and make it a full experience.

Trending Stays Worth the Hype in Santa Barbara
Find a cozy hotel nearby and make it a full experience.
Reviews
Live events

Mothers Circle
Wed, Feb 18 • 2:00 PM
400 West Pueblo St. santa barbara, CA 93105
View details

Santa Barbara Murder Mystery 2: Crime on Date Night!
Sun, Feb 1 • 12:00 AM
Anacapa St. & Anapamu St. Santa Barbara, CA, 93101
View details

Steve Poltz
Fri, Feb 13 • 3:00 AM
Soho Restaurant and Music Club, 1221 State Street, Santa Barbara, CA 93101, US, United States
View details
Nearby attractions of Beach City
Leadbetter Beach
Santa Barbara Carriage and Western Art Museum
La Playa Stadium
Pershing Park
Leadbetter Beach
Ledbetter Beach
Santa Barbara Harbor
Santa Barbara Maritime Museum
Outdoors Santa Barbara Visitor Center
Harbor Patrol

Leadbetter Beach
4.6
(918)
Open until 10:00 PM
Click for details

Santa Barbara Carriage and Western Art Museum
4.7
(99)
Open until 3:00 PM
Click for details
La Playa Stadium
4.8
(101)
Open 24 hours
Click for details

Pershing Park
4.3
(134)
Open until 8:00 PM
Click for details
Nearby restaurants of Beach City
Shoreline Cafe
Pressed Juicery
Brophy Bros.
On The Alley
Toma Restaurant & Bar
Rudy's Mexican Restaurant
The Anchor Rose
Sushi Go Go
Gracie
The Brewhouse

Shoreline Cafe
4.4
(870)
$
Open until 6:00 PM
Click for details

Pressed Juicery
4.4
(44)
$
Open until 9:00 PM
Click for details

Brophy Bros.
4.5
(1.8K)
$$
Open until 10:00 PM
Click for details

On The Alley
4.5
(365)
$
Open until 8:00 PM
Click for details
Nearby local services of Beach City
Hope Santa Barbara
Santa Barbara City College
El Rey Santa Barbara Carniceria
J J's Liquor & Wine
Santa Barbara Computer Repair
Santa Barbara Sailing Center
Santa Barbara Channel Charters
Saturday Fishermen's Market of Santa Barbara
Santa Barbara Harbor
Boat Launch Mini Mart

Hope Santa Barbara
4.7
(9)
Click for details

Santa Barbara City College
4.4
(139)
Click for details

El Rey Santa Barbara Carniceria
4.3
(447)
Click for details

J J's Liquor & Wine
3.9
(37)
Click for details
The hit list

Plan your trip with Wanderboat
Welcome to Wanderboat AI, your AI search for local Eats and Fun, designed to help you explore your city and the world with ease.
Powered by Wanderboat AI trip planner.